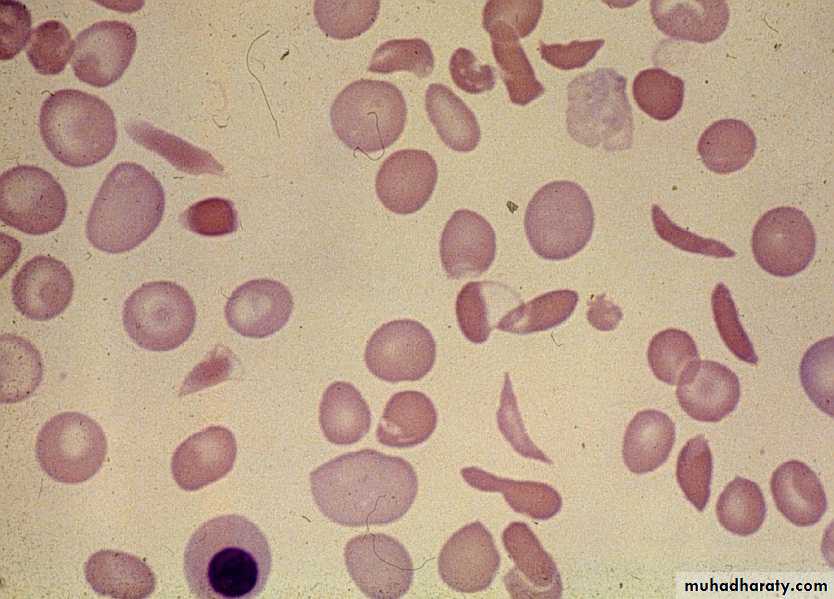

Fifth stage
medicineLec-
د.نزار
2/11/2015
HEMOGLOBINOPATHIES• Definition :Hemoglobinopathies are inherited disorders inwhich Mutation in or near the globin genes alterthe structure of amino acid sequences or the rateof synthesis of a particular globin chain.Hb-S B6 glu valHb-C B6 glu lysDefective haemoglobinSickle cell anaemia• It results from single base change inthe DNA coding for the amino acid inthe sixth position in the b-globin chain.• This leads to an amino acid changefrom glutamic acid to valine HbS willbe formed instead of the normal Hb.
• Sickle Cell Anemia is ahereditary disease which iscause by a disorder in theblood, a mutation in theHemoglobin Beta Gene whichcan be found in thechromosome 11. This diseasecauses the body to makeabnormally shapes red bloodcells. A normal red blood cellis shaped as a round donutwhile the abnormal red bloodcell has a “ C “ form.
• Hb S is insoluble and forms crystals when exposed tolow oxygen tension.• Deoxygenated sickle Hb polymerizes into long fibrils.• The red cells sickle may block the different areas ofthe microcirculation or large vessels causing infarctsof various organs.• It is widespread in Africa. Individuals withsickle-cell trait are relatively resistant to the lethaleffects of falciparum malaria in early childhood.
INTRODUCTION CONT’
Hemoglobin Beta Gene (HB-B) also known asBeta Globin is a protein that resides in the redblood cells.The HBB is 146 amino acids long and itsmolecular weight is 15,867 Daltons.The molecules of the hemoglobin areresponsible to carry oxygen through the body.The HBB is found in part 15.5 of thechromosome 11.
Pathophysiological effects of sickled cells1.Extravascular hemolysis .2. Loss of splenic function.3.Anaemia.4.Compromisation of the microcirculation.
CLINICAL MANIFESTATION1.complication from moderate to severeanaemia2.slowed growth and development .3.cardiac over load leads to CHF .4.Bilirubin stones and cholecystitis .5.Aplastic crisis.
Sickle cell crisis.1.Splenic crisis (splenic sequestration syndrome,auto splenectomy)2.Infections.3.CNS and ophthalmic events (CVA, proliferativeretinopathy).4.Acute chest syndrome (chromic pulmonary hypertension lead to cor-pulmonale).5.GIT : diffuse abdominal Pain.6.Genitourinary symptoms:- Painless haematuria.- hyposthenuia.- priapism.- hypogonadism.Sickle cell crisis Cont.7.skeletal complication
- hand-foot syndrome.acute arthritis.aseptic necrosis of the head of femur.osteomyelitis .8.Skin changes lead to chronic non-healing ulcer
DIAGNOSISPeripheral blood smears :sickled cells, target cells, Howell-Jolly bodies, normoblast,red cell fragment, increase platelet and occasionallyleukocytosis.screening test : sickling testThe presence of HbS can be demonstrated by exposing redcells to a reducing agent such as sodium dithionite; HbAgives a clear solution,whereas HbS polymerises to produce aturbid solution.Definitive diagnosis byHemoglobin electrophoresis (Hb-S =87% , Hb-F = 9.7%, Hb-A2 = 3.3%)
Howell Jolly BodyErythroblast
Diagnosis of sickle cell anaemia Cont.Haemoglobin Electrophoresis:Hb A 0 %Hb S 87.0 %Hb F 9.7 %Hb A2 3.3 %Both parents of the affected individual will havesickle-cell trait
TREATMENTPainful vaso-occlusive crisis1.hydration2.precepitating factors3.oxygen therapy4.analgesic5.exchange transfusion*Antisickling agent (Hydroxyurea) increase Hb Freduce sickling.*Bone marrow transplantation(Allogeneic-BMT).* Gene therapy.maintenance therapy and prevention1.folic acid 1 mg/d orally.2.pneumococcal vaccine.3.pregnancy (increase crisis, abortion, stillbirth) folate,, exchange transfusion. Exchange transfusion will increase Hb-A= 60%.4.general anesthesia;Careful hydration andoxygenation.*Angiographic contrast media causing sickling shouldbe avoided
The thalassemia syndromes
are inherited disorders arising from globingene mutations that either reduce or totallyabolish the synthesis of one or more globinchains.These imbalance in chain synthesis lead toformation of unstable Hb. or decrease Hb. lead tohypochromic microcytic anaemia .The thalassaemia named according to globinchain involved.THALASSEMIAPathophysiology of thalassemiaα- thalassemia, gene deletions areresponsible for the decrease or absence ofα- chains.ß- thalassemia : usually due to an mRNAabnormality.This mutation reduces or eliminates theproduction of ß-globin chains
Clinical manifestations of thalassemiaß- thalassemia major (ßoßo): is the most severe -Becomes apparent 3-6 months after birth when switchfrom Hb-F to Hb-A takes place :Hepatosplenomegaly (gall stones are also common )Expansion of the bones (hair on end appearance onskull X-ray examination).Severe anaemia with growth retardation and delayedsexual developmentDamage to heart, pancreas, endocrines and liver due toiron over load
Pathogenesis of anaemia of ß-thala.Decreased B- globin production has two major •consequences :total Hb. synthesis is reduced leading tomicrocytic anaemia, low level of Hb-A lead toincrease Hb-A2,Hb-F.free α-chain accumulates in the RBCα-chain accumulate and precipitate inRBC lead to hemolysis, destruction of RBC in the BM.
Pathogenesis cont.
The extent to which ß-chain synthesis issuppressed determine the degree ofanaemia(ineffective erythropoiesis)Extramedullary hematopoiesis andincreased erythropoiesis in the BM lead toover all RBC production is increased due toaccumalation of α chain.
DIAGNOSIS OF ß-THALASSAEMIAPositive family history with:a.non specific findings :Blood smear reveals microcytic RBCs,poikilocytosis, fragmented RBCs, MCV is low(around 65fl).Heinz bodies are evident by supravital stains.b. specific findings :Definitive diagnosis of ß-thala. Is based on thefollowing findings on Hb. Electrophoresis :increased proportion of Hb-A2(> 3.5%).increased proportion of Hb-F.
α –thalassaemia
Decrease synthesis of a-chains, lead to precipitation ofHb-H (4-ß chains) or Hb- Bart’s (4 δ-chains)Classification of α -thalassaemia :1-Hydrops fetalis : severe, all 4 α -genes aredeleted lead to severely anaemic, edematous,stillborn infant. Hb-barts (4 δ -chains had veryhigh oxygen affinity).α-THALASSAEMIAS•αThalassemia cont.2- HbH disease : deletion of 3 α -geneslead to unstable Hb. result in precipitationand extra-vascular hemolysis.3-α -thalassaemia Trait : deletion of 2 α genes.4-α-thalassaemia Carrier: deletion of 1 αgene, asymptomatic.DIAGNOSIS OF α-THALAPositive family history with lab finding •non specific findings :Blood smear show microcytic,hypochromic red cells, target cells, anisopoikilocytosis, and decrease MCV.Heinz bodies are evident.Specific findings : definitive diagnosis isfinding of HbH by Hb electrophoresis.34
Hb –H Diagnosis
Haemoglobin Electrophoresis: Hb A 91.5 %Fast moving band 8.5%
Hb A2 and Hb F decreased
Hb H Preparation
TREATMENT OF α- AND ß- THALASSEMIA1.Regular red cell transfusions :hypertransfusion program (keep the level ofHb>110g/L)2.Neocytes transfusion (increase RBC survival, decrease frequency of transfusion, anddecrease iron over load).2-3 units every 4-6 weeks .3.Leukocyte filter will lowers rate of transfusionreaction.4.Folic acid supplementation (5 mg) to preventaplastic crisis.5.Iron chelation:*Desferioxamine (Desferal) either with each unitof transfused blood (2 g) or by slowsubcutaneous daily infusions by pump(1-4g over 8-12(*(Exjade ) Deferasirox*Deferiprone6.Splenectomy ;indication:mechanical difficulty,hypersplenism.7.Bone Marrow Transplantation : prior todevelopment of hepatomegaly, portal fibrosis &iron over load.
PRENATAL DIAGNOSIS OF THALASSAEMIAGuide parents and physicians in decidingwhether to complete pregnancy.Both parent carriers.Fetal diagnosis:fetoscope to sample fetal venous blood show α/ßchain synthesis ratio.Amniocentesis or trophoblast (chorionic villus)biopsy for DAN analysis using DNA probes.IMMUNE HEMOLYSISDefinition :red cell life span is shortened becauseabnormalities in the components of the immunesystem are specifically directed against thepatients own erythrocytes.1.Auto-immune hemolytic anaemia.2.Transfusion related hemolysis.3.Drug-related immune hemolysis.AUTO- IMMUNE HEMOLYTIC ANAEMIAThe auto antibodies can be activated by eitherheat or cold.Warm reactive auto immune hemolysis (37oC)Causes :1- idiopathic2- secondary :I. Drugs (Methyldopa)II. Connective tissue disease (SLE)III. Lymphoproliferative (CLL, HD, NHL)CLINICAL MANIFESTATIONOnset rapid lead to anaemia, tiredness,fatigue.Elderly pts. With atherosclerosis lead tochest pain.Splenomegaly and Jaundice, may be absentin acute phase.Abdominal pain and fever may also occur.Diagnosisspherocytosis, reticulocytosis, increaseLDH, decrease serum haptoglolbin,increase indirect bilirubinpositive direct coomb’s test; Patient’sCELLS are tested for surface Ab’s
Treatment1.Removal of the underlying cause2.Corticosteroid : 1mg/kg prednisone (3-4weeks / check-Hb. & retics.) then slow taperingif pt. respond . in chronic cases, use low dosetherapy3.Splenectomy : in case of steroid failure ordecrease Hb. following cessation / reduction ofsteroid.4.Blood transfusion.*cold-reactive auto immune hemolysisAuto Antibodies usually are IgM. OccasionallyIgG.Low temp make the antigen(Ag) more prominenton the membrane lead to antibodies reaction.Warm temp hiding the Ag below the membranebelow the lipid component lead to prevention ofAg-Antibodies(Ag-Ab.) reactionCAUSES1.Idiopathic.2.Secondary:*Infection(mycoplasma pneumonia,infectious mononucleosis)*LymphomaPathogenesis and clinical effectsThe Blood from warm body cavities come to the surfacelow blood temp.this lead to activation of the autoAbsand to agglutination resulting in impairing circulationand producing cyanosis, pallor and ischemic pain(Raynauds phenomenon).IgM binds Ag temporarily, but it fixes complement. IgMdis-engages from red cell to a attach to another cell.The fixed complement remains and activate C5-C6causing hemolysis . C3-sensitized RBC removed by kuppfer cells in the liver and this why hemolysis notrespond to splenectomy.